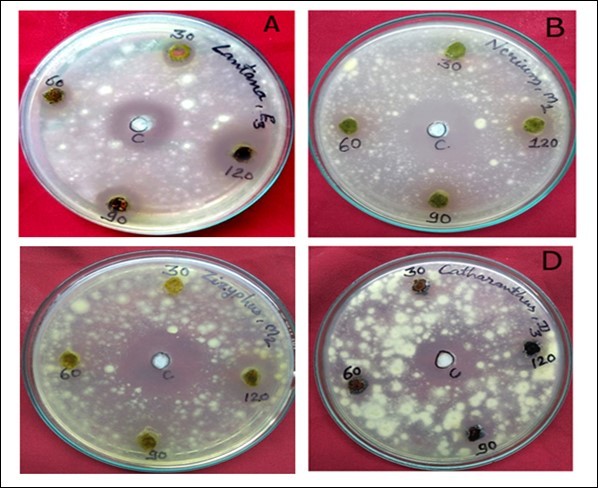

Antimycotic Activity of Leaf Extracts of Medicinal Plants Against Dermatophytes
Abstract
Plant products have been used as medicines against fungal infectious diseases. In this research antimycotic activity of the leaf extracts of five medicinal plants (Nerium indicum, Catheranthus roseus, Lantana camera, Ziziphus mauritiana) were tested against three dermatophytes (Trichophyton mentagrophytes, Trichophyton rubrum and Microsporum. gypseum). Development of more effective and less toxic antimycotic agents is required for the treatment of dermatophytosis. The plant materials were extracted with methanol, ethanol and diethyl ether solvent to investigate their antimycotic activities in Vitro. Ethanol and methanol extracts of all selected medicinal plants were showed the positive activity against all tested dermatophytes. Diethyl ether extract was showed lowest activity against T. mentagrophytes and T. rubrum and showed moderate activity against M. gypseum. The three dermatophytes differed with regard to their susceptibility to plant extracts.
Author Contributions
Academic Editor: Samantha Chandranath Karunarathna, Kunming Institute of Botany, Chinese Academy of Sciences, Kunming, China.
Checked for plagiarism: Yes
Review by: Single-blind
Copyright © 2020 Renu Jangid, et al.
This is an open-access article distributed under the terms of the Creative Commons Attribution License, which permits unrestricted use, distribution, and reproduction in any medium, provided the original author and source are credited.
Competing interests
The authors have declared that no competing interests exist.
Citation:
Introduction
Plants have been considered a valuable source of natural products for maintaining human health. Plants have a long history of antibiotic usage for the cure of infectious disease, caused by pathogenic micro-organisms. Plant and their product have been used since ancient times for medicinal purpose. Much attention has been refocused on plant origin of antimicrobial and anti dermatophytic agents, after the discovery of penicillin. This is considered to be one of the most important life-saving Phyto-drugs.
Plants are a primary source of new natural medicinal products 1. The antimicrobial activities of plant extracts have formed the basis of many applications, including raw and processed food preservation, pharmaceuticals, alternative medicine and natural therapies 2. Medicinal plants represent a rich source of secondary metabolites, many of which possess antimicrobial properties. Secondary metabolites enhance the overall capacity of it to survive and prepare to face challenges by giving them ability to interact with their environment 3. Thus, screening of medicinal plants provides another alternative for producing chemical fungicides that are relatively non-toxic and cost-effective.
Natural products are generally harmless or have minimum side effects as compared to synthetic drugs. Plant products are safe to humans and the ecosystems than the chemical antimicrobial components, and can easily be used by the people have used medicinal plants for thousands of years to enhance flavour and aroma of foods as well as its economic value 4, 5.
A number of reports are available in vitro and in vivo efficacy of plant extract against plant and human pathogens causing fungal infections 6. The activity of plant extract against dermatophytosis i.e. the fungal infections of skin or keratinized tissue of human beings can be very well visualized from the reports of Venugopal 7.
The antifungal activity of plant essential oils extracted by steam distillation from seven different plant species including Cinnamon, Anise, Clove, Citronella, Peppermint, pepper, and Camphor was investigated by Fei hue 8.
According to a research Mo-CBP4 (chitin-bindingprotein) is purified from Moringa oleifera seeds showed anti-dermatophytic activity 9.
There are few different classes of effective antifungal drugs available for the treatment of fungal diseases of plants, animals and humans. Thus, it is important to develop new sources of antifungal agents.
In the present study, four medicinal plants viz. Nerium indicum, Catheranthus roseus, Lantana camera, Ziziphus mauritianahave been chosen for the investigation of in vitro antimycotic activity against selected dermatophytes. All selected medicinal plants are used as traditional medicine in different parts of the world. C. roseus possesses known antibacterial, antifungal, antidiabetic, anticancer and antiviral activity.
Material & Methods
Fungal Material
Three dermatophytes selected for antimycotic activity. All three cultures were isolated from soil samples by Hair Baiting Technique.
Culture Media
The isolated fungus culture was maintained on Sabouraud’s Dextrose Agar Media.
Plant Material
The leaves of four medicinal plants viz., Nerium indicum, Ziziphus mauritiana, Catheranthus roseus and Lantana camera were collected from spring and summer seasons in the local area of Ajmer district, Rajasthan. Plant material authenticated by Department of Botany, Samrat Prithviraj Chouhan, Govt. College, Ajmer, Rajasthan. The collected leaves were washed in running tap water to remove dust, blotted with filter paper and dried in the shade. After then dried leaf material was ground into powder and sealed in polythene bags for further use.
Preparation of Leaf Extracts
Plant extract was prepared by Soxhlet extraction method. About 10gm of dried and powdered plant sample (Lantana camera, Ziziphus mauritiana, Nerium indicum and Catharanthus roseus) was uniformly packed in to a thimble and run in Soxhlet extractor with ethanol/ methanol/ ethyl ether (100ml) for 48h. The extract was then filtered with the help of filter paper and solvent was evaporated from extract and dried in pre-weight petri-plates. After dried plant material again measured weight of petri-plates. The extracts were kept in refrigerator at 400C for further experiments.
Antimycotic Activity
Antimycotic activity of the experimental plants were investigated by Agar well diffusion assay with slight modification 10. The fungal cultures were sub-cultured onto Sabouraud’s Dextrose Agar, SDA (Merck, Germany) and respectively incubated at 30°C for 24 h. Suspensions of fungal spores were prepared in PBS and adjusted to a concentration of 106cells/ml. Inoculate test fungus into sterilised 10ml medium in tubes, mix well by rolling it gently between the palms. Pour it to the surface of the base agar and the plates were dried at room temperature for 15 min in LAF. Wells of 10 mm in diameter and about 7 mm apart were punctured in the culture media using sterile glass tube. 30, 60, 90 and 120 µl of several dilutions of fresh extracts made in methanol, diethyl ether and ethanol were administered to respective for each well and 40 µl ketoconazole antifungal drug was used as standard. Plates were incubated at 30°C. After incubation of 24 h bioactivities were determined by measuring the diameter of inhibition zone (in mm). All experiments were made in triplicate and means were calculated.
Control Experiment
The presence of inhibition of the treated fungus was calculated using Ketoconazole as standard.
Result
In the present study the antimycotic activity of leaf extracts were investigated. The data on selected dermatophyte isolated from soils of Ajmer district (Rajasthan). Antimycotic activity of different leaf extracts against human pathogenic fungi (T. mentagrophytes, T. rubrum and M. gypseum) was evaluated by the Agar well diffusion method. The results and screening of antimycotic activity of leaf extracts of selected medicinal plants (Lantana camera, Ziziphus mauritiana, Nerium indicum and Catheranthus roseus) are summarized in Table 1, Table 2, Table 3, Table 4, Table 5. All the leaf extracts tested exhibited different degrees of antimycotic activity against T. mentagrophytes, T. rubrum and M. gypseum. The ethanol extract exhibited highest antimycotic activity and diethyl ether showed the lowest antimycotic activity against all three dermatophytes used in this study.
Table 1. Antimycotic activity of leaf extracts of Catheranthus roseus against selected dermatophytes.| S.No. | Isolates | Extracts | Control | Inhibition Zone(mm) at different conc. | |||
| 30µl | 60 µl | 90 µl | 120 µl | ||||
| 1. | T. mentagrophytes | Methanol | 30 | Nil | 12 | 16 | 17 |
| Ethanol | 30 | 10 | 13 | 14 | 24 | ||
| Diethyl ether | 25 | Nil | 6 | 8 | 12 | ||
| 2. | T. rubrum | Methanol | 30 | Nil | 12 | 16 | 22 |
| Ethanol | 30 | Nil | 11 | 15 | 16 | ||
| Diethyl ether | 27 | Nil | 8 | 14 | 14 | ||
| 3. | M. gypseum | Methanol | 25 | 10 | 13 | 15 | 18 |
| Ethanol | 25 | 11 | 14 | 16 | 19 | ||
| Diethyl ether | 25 | 10 | 11 | 13 | 14 | ||
| S.No. | Isolates | Extracts | Control | Inhibition Zone(mm) at different conc. | |||
| 30µl | 60 µl | 90 µl | 120 µl | ||||
| 1. | T. mentagrophytes | Methanol | 30 | 11 | 13 | 16 | 20 |
| Ethanol | 30 | 10 | 15 | 20 | 25 | ||
| Diethyl ether | 25 | Nil | 6 | 8 | 12 | ||
| 2. | T. rubrum | Methanol | 30 | Nil | 13 | 11 | 18 |
| Ethanol | 30 | Nil | 14 | 16 | 20 | ||
| Diethyl ether | 27 | Nil | 8 | 12 | 15 | ||
| 3. | M. gypseum | Methanol | 25 | 10 | 14 | 16 | 19 |
| Ethanol | 25 | 11 | 13 | 15 | 24 | ||
| Diethyl ether | 25 | 10 | 11 | 13 | 15 | ||
| S.No. | Isolates | Extracts | Control | Inhibition Zone(mm) at different conc. | |||
| 30µl | 60 µl | 90 µl | 120 µl | ||||
| 1. | T.mentagrophytes | Methanol | 30 | 11 | 12 | 14 | 16 |
| Ethanol | 30 | Nil | 12 | 18 | 22 | ||
| Diethyl ether | 25 | Nil | 6 | 11 | 14 | ||
| 2. | T. rubrum | Methanol | 30 | Nil | 8 | 15 | 18 |
| Ethanol | 30 | 11 | 12 | 13 | 15 | ||
| Diethyl ether | 27 | Nil | Nil | Nil | Nil | ||
| 3. | M. gypseum | Methanol | 25 | Nil | 11 | 15 | 17 |
| Ethanol | 25 | 10 | 11 | 13 | 16 | ||
| Diethyl ether | 25 | 11 | 12 | 14 | 16 | ||
| S.No. | Isolates | Extracts | Control | Inhibition Zone(mm) at different conc. | |||
| 30µl | 60 µl | 90 µl | 120 µl | ||||
| 1. | T. mentagrophytes | Methanol | 30 | Nil | 12 | 16 | 18 |
| Ethanol | 30 | 12 | 14 | 16 | 19 | ||
| Diethyl ether | 25 | Nil | 6 | 8 | 10 | ||
| 2. | T. rubrum | Methanol | 30 | Nil | 10 | 15 | 20 |
| Ethanol | 30 | 11 | 13 | 16 | 17 | ||
| Diethyl ether | 27 | Nil | Nil | Nil | Nil | ||
| 3. | M. gypseum | Methanol | 25 | 10 | 15 | 17 | 20 |
| Ethanol | 25 | 11 | 13 | 16 | 20 | ||
| Diethyl ether | 25 | 10 | 11 | 13 | 14 | ||
| S. No. | Isolates | Extracts | Control | Inhibition compared to ketoconazole in % | |||
| Catheranthus | Lantana | Nerium | Ziziphus | ||||
| 1. | T. mentagrophytes | Methanol | 100 | 57 | 67 | 53 | 60 |
| Ethanol | 100 | 70 | 83 | 73 | 63 | ||
| Diethyl ether | 100 | 48 | 0 | 56 | 40 | ||
| 2. | T. rubrum | Methanol | 100 | 73 | 60 | 60 | 67 |
| Ethanol | 100 | 53 | 67 | 50 | 57 | ||
| Diethyl ether | 100 | 52 | 56 | 0 | 0 | ||
| 3. | M. gypseum | Methanol | 100 | 72 | 76 | 68 | 80 |
| Ethanol | 100 | 76 | 96 | 64 | 80 | ||
| Diethyl ether | 100 | 56 | 60 | 64 | 56 | ||
Antimycotic Activity of Different Leaf Extracts
Catheranthus Roseus
Ethanol extract was showed the good activity and diethyl ether was showed moderated activity against all selected dermatophytes. Methanol extract showed good activity against T. rubrum and moderate activity against T. mentagrophytes and M. gypseum. Ethanol extract was showed highest % inhibition (76) against M. gypseum compared to standard.
Lantana Camera
Diethyl ether extract was not found effective against T. mentagrophytes and T. rubrum and was showed moderated activity against M. gypseum inhibition zones were of each 14mm(120µl). Both methanol and ethanol extracts were showed effective activity against all three dermatophytes. The highest activity was measured in ethanol extract and inhibition zone of 25, 20, and 24mm were recorded for T. mentagrophytes, T rubrum and M. gypseum. Ethanol extract was showed highest % inhibition (96) against M. gypseumcompared to standard.
Nerium Indicum
Diethyl ether showed negative activity against T. rubrum and moderator activity showed against M. gypseum and T. mentagrophytes. Ethanol extract exhibited best activity against T. mentagrophytes and inhibition zone of 22mm. Methanol extract moderate activity against all three dermatophytes. Ethanol extract was showed highest % inhibition (73) against T. mentagrophytes compared to standard.
Ziziphus Mauritiana
Both ethanol and methanol extract exhibited antimycotic activity against all three dermatophytes. Diethyl ether extract showed positive activity against only M. gypseum and showed negative activity against T. mentagrophytes and T. rubrum. Both ethanol and methanol extracts were showed highest % inhibition 80,80against M. gypseum compared to standard. Figure 1 and Figure 2.
Figure 1.Antimycotic Activity of Different Leaf Extracts of Medicinal Plants. (A) Petridish showing activity of Ethanol extracted from Lantana camera against M. gypseum. (B) Activity of Methanol extracted from Nerium indicum against T. mentagrophytes. (C) Activity of Diethyl extracted from Ziziphus mauritiana against M. gypseum. (D) Activity of Diethyl ether extracted from Catheranthus roseus against M. gypseum.
Figure 2.The % inhibition of different leaf extracts compared to ketoconazole (100% inhibition) against tested dermatophytes.
Discussion
Plant are important source of natural products for the development of new therapeutic agents. Many reports are available on the antiviral, antimicrobial and anti-inflammatory properties of plants. Some of these observations have helped in developing drugs for the therapeutic use in human beings.
In present study the methanol, ethanol and diethyl extracts of selected medicinal plants (Nerium indicum, Catheranthus roseus, Lantana camera, Ziziphus mauritiana) showed the activity against selected dermatophytes. The extract from leaves of C. roseus was showed significant antimicrobial potential against fungi and bacterial strains as well astwo human cancer cell lines 11. Taoubi reported antiseptic, antitumoural, and antimicrobial potential in Leaf extracts of Lantana camera. There are numerous antifungal agents used clinically to treat fungal infections 12. The methanol leaf extracts of Sida cordifolia, Ziziphus mauritiana, Acacia nilotica, Tinospora cordifolia, and Withaniasomnifer showed significant antibacterial activity against Bacillus subtilis, Escherichia coli, Pseudomonas fluorescens, Staphylococcus aureus and Xanthomonas axonopodismalvacearum and antifungal activity against Aspergillus flavus, Dreschlera turcica and Fusarium verticillioide13. N. indicum is one such plant which is used extensively in ethnomedicinal practices all over the world for the treatment of dermatitis, skin cancer, ringworm, scabies, epilepsy, asthma, malaria, and heart disease etc. In Iloilo, Philippines, the plant is used as ethnomedicine to treat fever, headache, and dermatological problems. 14.
Plant based products have been effectively proven for their utilization as source for antifungal and antibacterial compounds. It is important to investigate scientifically those plant products which have been used in drugs as potential sources of antimycotic compounds 15. Research on new antimycotic substances should be continued and small molecules from medicinal chemistry as well as plant products are still major sources of innovative therapeutic agents for infectious fungal diseases 16.
The results of present investigation clearly indicate that antimycotic activity vary with the species of plants. All the extracts tested exhibited different degrees of antimycotic activity. Ethanol and Methanol both extracts showed effective inhibitory activity and diethyl ether showed moderated activity against selected dermatophytes in this study. Thus, the study ascertains the importance of plant products used in Ayurveda, when could be of considerable interest to the development of new drugs.
Conclusion
At present fungal infections have become an important clinical threat which is due to the development of fungal resistance to the existing antifungal agents. The conclusion of this study aspects the traditional medicine use of various plant extracts in treating different infectious diseases caused by fungus. It also suggests that a great attention to medicinal plants which are found plenty of pharmacological properties. Thus, Medicinal plants were the best source of various novel pharmaceutical products which effect on the human beings and improve human and animal health.
Acknowledgment
The authors are grateful to Dr. Tahira (Associate Professor), from Department of Botany, Samrat Prithviraj Chauhan Government College Ajmer, Rajasthan, India. and are also thankful to CSIR for providing financial support.
Author’s Profile
Ms. Renu Jangid is a research scholar, Department of Botany, Samrat Prithviraj Chauhan Government College Ajmer, Rajasthan, India. She has completed M.Sc. Degree in Botany from Samrat Prithviraj Chauhan Government College Ajmer, Rajasthan, India. Retired Dr. Tahira (Associate Professor), from Department of Botany, Samrat Prithviraj Chauhan Government College Ajmer, Rajasthan, India. She has awarded with a Ph.D degree in Botany from Maharshi Dayanand Saraswati University, Ajmer, Rajasthan, India.
References
- 1.Hostettman K. (1999) Strategy for the biological and chemical evaluation of plant extracts. , IUPAC
- 2.Lis-Balchin M, S G Deans. (1997) Bioactivity of selected plant essential oils against Listeria monocytogenes. , J. Appl. Bacteriol 82, 759-762.
- 5.Shelef L A, Jyothi E K, Bulgarelli M. (1984) Effect of sage on growth of enteropathogenic and spoilage bacteria in sage-containing broths and foods. , J. Food Sci 49, 737-740.
- 6.Natarajan V, P V Venugopal, Menon T. (2003) Effect of Azadirachta indica (neem) on the growth pattern of dermatophytes. , Indian J. Med. Microbiol 21, 98-10.
- 7.P V Venugopal, T V Venugopal. (1995) Antidermatophytic activity of Garlic (Allium sativum) in Vitro. , Int. J. Dermatol 34, 278-289.
- 8.Bonjar G H. (2005) Antibacterial screening of plants used in Iranian folkloric medicine.75:. 231-235.
- 9.Fei H, Zhao-Jun W. (2019) Comparison of antifungal activity of essential oils from different plants against three fungi. Food and Chemical Toxicology. 134, 110821.
- 10.Tiago D P L. (2020) Mo-CBP4, a purified chitin-binding protein from Mangifera oleifera seeds, is a potent anti-dermatophytic protein: In vitro mechanisms of action, in vivo effect against infection, and clinical application as a hydrogel for skin infection. , Int. J. of Biological Macromolecules 149, 432-442.
- 11.A, H S Mona, Mohamed A, Elkelish A. (2020) Changes in Ecophysiology, osmolytes, and Secondary metabolites of the Medicinal Plants of Menta piperita and C. roseus subjected to Drought and Heat stress. , Biomolecules 10(1), 43.
- 12.Taoubi K, Fauvel M T, Gleye J, Moulis C. (1997) . Phenylpropanoid glycosides from Lantana camara and Lippia multiflora. Planta Medica.63: 192-193.
- 13.Tantiado R G. (2012) Survey on ethnopharmacology of medicinal plants in Iloilo. , Philippines. Int J Biosci Biotechnol 4, 11-26.
- 14.Mahesh B, Satish S. (2008) Antimicrobial activity of some important medicinal plant against plant and human pathogens. , World J. Agric. Sci 4, 839-843.
Cited by (3)
This article has been cited by 3 scholarly works according to:
Citing Articles:
Research Journal of Pharmacy and Technology (2025) Crossref
Sri Rezeki, Diana S. Ningsih, Subhaini Jakfar, A. I. Nasution, Basri A. Gani - Research Journal of Pharmacy and Technology (2025) Semantic Scholar
Research Journal of Pharmacy and Technology (2025) OpenAlex
INTERNATIONAL JOURNAL OF ENDORSING HEALTH SCIENCE RESEARCH (IJEHSR) (2021) OpenAlex
